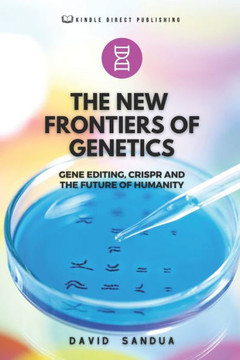
The New Frontiers of Genetics: Gene Editing, Crispr and the Future of Humanity

Rose Publishing (CA)
Genetic Precision CRISPR Revolution
Product Code:
9788196928506
ISBN13:
9788196928506
Condition:
New
$31.00
$28.34
Sale 9%

Genetic Precision CRISPR Revolution
$31.00
$28.34
Sale 9%
Hereditary Accuracy: CRISPR Transformation is a convincing investigation of the earth shattering headways in hereditary altering achieved by CRISPR innovation. The book starts with a sagacious outline in Section 1, diving into the set of experiences and revelation of CRISPR and establishing the groundwork for understanding the significant effect it has had on the field of hereditary qualities. The atomic complexities of CRISPR-Cas9 innovation are fastidiously made sense of, featuring its accuracy in focusing on unambiguous qualities. This part fills in as an introduction for perusers new to the innovation, laying out a strong comprehension of the logical standards behind CRISPR. In Section 2, "The Force of Accuracy," the book brings a more profound plunge into the unrivaled accuracy that CRISPR brings to hereditary altering. Through a thorough investigation of its capacities in focusing on unambiguous qualities, the part draws examinations with conventional hereditary altering techniques. Certifiable instances of fruitful CRISPR applications are introduced, showing the extraordinary capability of this innovation in changing the hereditary scene with uncommon precision. In any case, as the commitment of CRISPR unfurls, Section 3, "Moral Contemplations," stands up to the moral situations encompassing its utilization. The book basically looks at possible abuse and potentially negative side-effects, inciting perusers to contemplate the moral components of fiddling with the major structure blocks of life. Worldwide points of view on CRISPR morals are investigated, giving a nuanced comprehension of the changed viewpoints and worries that emerge in various social and cultural settings. The fourth section, "Illness Annihilation," centers around how CRISPR is upsetting the treatment of hereditary sicknesses. The story explores through a top to bottom examination of CRISPR's application in focusing on and dispensing with explicit hereditary problems. The section presents convincing contextual investigations of fruitful CRISPR mediations in ailments, offering a brief look into a future where hereditary sicknesses can be successfully treated or even destroyed. Moving the concentration to agribusiness, Section 5, "Horticulture and CRISPR," investigates the effect of CRISPR on food creation. The book features hereditarily changed crops and their expected advantages, revealing insight into how CRISPR innovation is reshaping the scene of farming hereditary altering. The section likewise digs into the contentions and difficulties related with hereditarily changed life forms, giving a reasonable viewpoint on the mind boggling transaction between science, farming, and cultural worries. Part 6, "Development of CRISPR Innovation," gives a keen investigate the most recent progressions in CRISPR. It covers the continuous innovative work, displaying better than ever CRISPR variations. The part investigates the cooperative idea of logical advancement, accentuating how the worldwide academic local area adds to the persistent development of CRISPR innovation.
| Author: Mack Rafeal |
| Publisher: Rose Publishing (CA) |
| Publication Date: Jan 23, 2024 |
| Number of Pages: NA pages |
| Language: English |
| Binding: Paperback |
| ISBN-10: 8196928505 |
| ISBN-13: 9788196928506 |